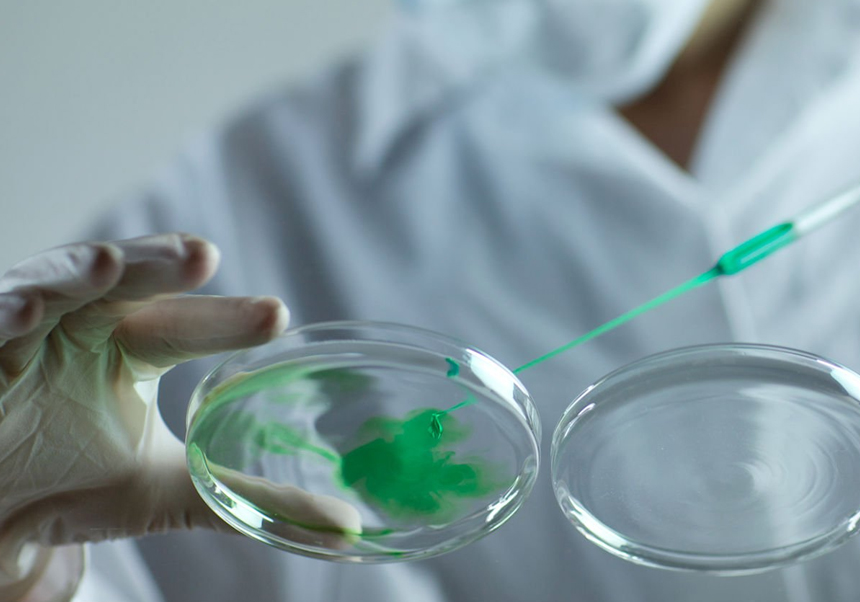

Users
Social media
- More details here...
- Address
Parc Científic de la Universitat de València C/
Catedrático Agustín Escardino, 9
46980 Paterna (Valencia) Spain - Email:
iu.i2sysbio@uv.es - Phone:
(+34) 963544810
- Address
Links
Lab Technician Job Offer

Investigation & Education
Thesis
Lab Technician Job Offer
We are looking for a laboratory technician with a broad experience in genetic engineering (cloning, including Gibson and Golden Gate methods).
Requirements:
- At least MSc (or equivalent) in a relevant scientific discipline
- At least two years of wet lab experience
- Knowledge in bacterial cultures
In addition, the candidate should have strong organizational skills, English proficiency and the ability to work independently. She/he will work in the research projects under the supervision of senior researchers. Occasionally will manage incoming students.
We value experience in: bacteriophages, knowledge in the use and management of bioreactors like Chi.Bio or similar and experience doing DNA libraries.
Applicants with a PhD from outside the EU, must have applied for doctoral degree equivalency through the Spanish academic system to be considered.
Who we are:
The Jaramillo Lab has an international experience of 20 years leading research in synthetic biology (at École Polytechnique, CNRS, University of Warwick) and supervising scientists (79 in the last 10 years), now established in Spain. We use innovative research approaches in microbiology, virology, synthetic biology, immunology and bioinformatics, incorporating advanced technology development including CRISPR/Cas technologies, advanced omics, genomic engineering and automated continuous culture bioreactors. We are located at the Institute for Integrative Systems Biology (I2Sysbio), in the Science Park of the University of Valencia.
Application:
Send CV and a motivation letter to joaquin.gomis@csic.es and joseph.white@csic.es